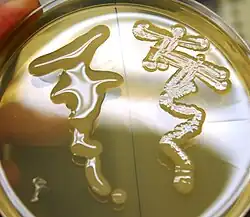

Lon (протеаза)
Lon (протеаза La) — сериновая протеаза в клетках бактерий, митохондриях и хлоропластах эукариот. Принадлежит к важной группе АТФ-зависимых протеаз, куда также относится протеасомы, ClpP , HslVU и FtsH. По классификации MEROPS относится к семейству S16[1].
Структура
Lon состоит из трёх доменов — а) N-концевого, функция которого до конца не известна, но, по-видимому, задействованного в распознавании субстратов[2]; б) АТФ-связывающего, осуществляющего гидролиз АТФ, разворачивание и перемещение полипептидных цепей в следующий, в) протеазный домен, где происходит расщепление субстрата на пептидные фрагменты[3]. Шесть таких белков соединяются вместе, образуя цилиндрический шестичленник-гексамер. Для расщепления полипептидная цепь должна попасть в развёрнутом виде внутрь цилиндра, где спрятан активный центр, что предотвращает действие Lon на случайные клеточные белки, не являющиеся субстратами. Напротив, белки-субстраты распознаются N-концевым доменом и перемещаются к активному центру АТФ-связывающим доменами белка[4]. Имеются данные, что два кольца-шестичленника могут соединяться вместе, составляя один большой цилиндр. Причём, похоже, соединяются они АТФ-связывающим и N-концевыми доменами, что отличает Lon от других членов группы, у которых отдельные кольца-многочленника соединены протеазными доменами. Предполагается, что шестичленник способен связывать большие белки или белковые комплексы, а двенадцатичленник — небольшие пептиды или развёрнутые белки, что позволяет регулировать протеолиз в клетке[5].
.jpg)
.jpg)
Механизм действия
Кристаллическая структура Lon показывает, что в активном центре находится каталитическая диада — Ser и Lys (в отличие от большинства сериновых протеаз, где каталитическую роль играют три аминокислоты — Ser, Asp и His)[6]. Исходя из экспериментальных данных, Lon не обладает специфичностью при расщеплении субстрата, проявляя лишь незначительное предпочтение к Leu, Phe и Ala в положении -1[7].
Распространение
Lon имеется почти у всех бактерий (за редким исключением), митохондриях и хлоропластах животных и растений. У некоторых бактерий (например у Bacillus subtilis) содержатся две и более формы Lon, обладающие разной функциональной специфичностью[8],[9].
Субстраты. Функциональное значение.
У Escherichii coli Lon выполняет множество функций. Lon является основной протеазой E. coli, которая распознаёт и разрушает неправильно свёрнутые или аггрегированные белки[10][11]. В поздней стационарной фазе роста, бактериальная клетка начинает разрушать свободные белки рибосом, чтобы восполнить нехватку аминокислот. Эту функцию также осуществляет Lon[12]. Двумя наиболее известными субстратами являются SulA и RcsA. SulA является ингибиторм клеточного деления, синтезируемым в ответ на повреждение клеточной ДНК. Инактивация Lon в клетках приводит к чувствительности к ультрафиолету — клетки синтезируют SulA, он не разрушается, клетки не делятся, растут в длинные филаменты и в конце концов погибают[13]. RcsA активирует транскрипцию ферментов, синтезирующих колановую кислоту — экзополисахарид, составляющий защитную капсулу бактерии. Соответственно, самый заметный фенотипический признак отсутствия Lon — слизистые колонии на чашках Петри[14].
Lon разрушает белки UmuD и UmuC, которые позволяют клетке синтезировать комплементарную цепь ДНК на повреждённой цепи (однако, совершая при этом множество ошибок). У UmuD Lon разрушает неактивную форму, в то время как активная форма UmuD’ разрушается ClpXP[15]. Lon разрушает оба основных структурных белка телец включения IbpA и IbpB[16]; активаторы транскрипции белков ответа на окислительный стресс SoxS и MarA[17]; а также многие из белков-антитоксинов токсин-антитоксиновых систем, включая CcdA, PemI, PasA, RelB и MazE[18][19]. У B. subtilis — два разных белка Lon: LonA и LonB. LonA участвует в инициации споруляции, в то время как LonB экспрессируется только в новообразующейся споре[9][20]; у Myxococcus xanthus один из двух генов Lon этого организма — LonD — вовлечён в регуляцию споруляции и формирование плодового тела[21]; у Proteus mirabilis Lon регулирует подвижность[22]; у Salmonella enterica, Pseudomonas syringae и Yersinia pestis — экспрессию компонентов Системы Секреции III Tипа, необходимой для взаимодействия с клетками организма хозяина[23][24][25]. В митохондриях эукариот Lon содержится в матриксе, где разрушает неправильно свёрнутые или повреждённые активными формами кислорода белки[26]. Самыми значимыми субстратами для него являются аконитаза, одна из субъединиц цитохром оксидазы и белок StAR (steroidogenic acute regulatory protein) [27][28][29].
Специфичность
Lon распознаёт короткие последовательности как на N- (UmuD)[30], так и на С-концах (SulA)[31] белков-субстратов. При этом какой-то общей последовательности для них не обнаружено. Сообщается, что у неправильно свёрнутых белков Lon распознаёт короткие гидрофобные участки, богатые ароматическими аминокислотными остатками[32].
Регуляция
Один из промотеров для транскрипции гена lon у E. coli распознаётся сигма фактором σ32, отвечающим за транскрипцию белков теплового шока. Это имеет очевидный смысл, поскольку Lon распознаёт неправильно свёрнутые белки, количество которых при тепловом шоке резко увеличено[33]. Также Lon связывается с поли-Р — полимером ортофосфата, синтезируемом в клетках E. coli в ответ на голодание. При этом меняется специфичность в сторону разрушения свободных рибосомных белков, что позволяет временно справиться с аминокислотным голодом[12]. Фаг Т4 синтезирует белок PinA, который специфически ингибирует Lon. Это вероятно говорит о том, что какие-то из важных для этого фага белков в нормальном состоянии являются субстратами для Lon[34].
Интересные факты
Штамм BL-21(DE3), широко используемый для экспрессии рекомбинантных белков является фенотипически Lon минус, так как родительский штамм E. coliB несёт мутацию инактивирующую Lon. Предполагается, что эта мутация увеличивает выход белков склонных к аггрегации или неправильному сворачиванию[35],[36].
Некоторые исследователи Lon митохондрий млекопитающих предполагают, что уменьшение активности этого белка может играть существенную роль в процессе старения [37].
Примечания
- ↑ Summary for family S16 Архивная копия от 4 марта 2016 на Wayback Machine — MEROPS
- ↑ Ebel et al. J Bacteriol. 1999 Apr;181(7):2236-43. Дата обращения: 3 октября 2017. Архивировано 29 января 2016 года.
- ↑ Wickner et al. Science. 1999 Dec 3;286(5446):1888-93. Дата обращения: 3 октября 2017. Архивировано 28 октября 2016 года.
- ↑ Park et al. Mol Cells. 2006 Feb 28;21(1):129-34. Дата обращения: 3 октября 2017. Архивировано 12 октября 2013 года.
- ↑ Vieux et al. Proc Natl Acad Sci U S A. 2013 May 28;110(22):E2002-8. doi: 10.1073/pnas.1307066110. Epub 2013 May 14. Дата обращения: 3 октября 2017. Архивировано 5 мая 2017 года.
- ↑ Botos et al. «The catalytic domain of Escherichia coli Lon protease has a unique fold and a Ser-Lys dyad in the active site». J Biol Chem. 2004 Feb 27; 279(9):8140-8. PMID 14665623
- ↑ Substrates for peptidase S16.001: Lon-A peptidase — MEROPS
- ↑ Riethdorf et al. J Bacteriol. 1994 Nov;176(21):6518-27. Дата обращения: 3 октября 2017. Архивировано 12 октября 2013 года.
- 1 2 Schmidt et al. J Bacteriol. 1994 Nov;176(21):6528-37. Дата обращения: 3 октября 2017. Архивировано 12 октября 2013 года.
- ↑ Shineberg and Zipser J Bacteriol. 1973 Dec;116(3):1469-71. Дата обращения: 3 октября 2017. Архивировано 12 октября 2013 года.
- ↑ Fredriksson et al. J Bacteriol. 2005 Jun;187(12):4207-13. Дата обращения: 3 октября 2017. Архивировано 12 октября 2013 года.
- 1 2 Kuroda et al. Science. 2001 Jul 27;293(5530):705-8. Дата обращения: 3 октября 2017. Архивировано 30 января 2016 года.
- ↑ Mizusawa and Gottesman. Proc Natl Acad Sci U S A. 1983 Jan;80(2):358-62. Дата обращения: 3 октября 2017. Архивировано 3 июня 2016 года.
- ↑ Markovitz Proc Natl Acad Sci U S A. 1964 Feb;51:239-46. Дата обращения: 3 октября 2017. Архивировано 12 октября 2013 года.
- ↑ Frank et al. Proc Natl Acad Sci U S A. 1996 Sep 17;93(19):10291-6. Дата обращения: 3 октября 2017. Архивировано 21 мая 2016 года.
- ↑ Bissonnette et al. Mol Microbiol. 2010 Mar;75(6):1539-49. doi: 10.1111/j.1365-2958.2010.07070.x. Epub 2010 Feb 10. Дата обращения: 3 октября 2017. Архивировано 5 мая 2017 года.
- ↑ Griffith et al. Mol Microbiol. 2004 Mar;51(6):1801-16. Дата обращения: 3 октября 2017. Архивировано 12 октября 2013 года.
- ↑ Christensen et al. «RelE, a global inhibitor of translation, is activated during nutritional stress». Proc Natl Acad Sci U S A. 2001 Dec 4; 98(25):14328-33. PMID 11717402
- ↑ Christensen et al. J «Toxin-antitoxin loci as stress-response-elements: ChpAK/MazF and ChpBK cleave translated RNAs and are counteracted by tmRNA».Mol Biol. 2003 Sep 26; 332(4):809-19. PMID 12972253
- ↑ Serrano et al. J Bacteriol. 2001 May;183(10):2995-3003. Дата обращения: 3 октября 2017. Архивировано 12 октября 2013 года.
- ↑ Kroos and Kaiser. «Expression of many developmentally regulated genes in Myxococcus depends on a sequence of cell interactions». Genes Dev. 1987 Oct; 1(8):840-54. PMID 2828174
- ↑ Claret and Hughes. J Bacteriol. 2000 Feb;182(3):833-6. Дата обращения: 3 октября 2017. Архивировано 12 октября 2013 года.
- ↑ Takaya et al. Mol Microbiol. 2005 Feb;55(3):839-52. Дата обращения: 3 октября 2017. Архивировано 20 мая 2016 года.
- ↑ Bretz et al. «Lon protease functions as a negative regulator of type III protein secretion in Pseudomonas syringae» Mol Microbiol. 2002 Jul; 45(2):397-409. PMID 12123452
- ↑ Jackson et al. Mol Microbiol. 2004 Dec;54(5):1364-78. Дата обращения: 3 октября 2017. Архивировано 12 октября 2013 года.
- ↑ Voos. Biochim Biophys Acta. 2013 Feb;1833(2):388-99. doi: 10.1016/j.bbamcr.2012.06.005. Epub 2012 Jun 13. Дата обращения: 3 октября 2017. Архивировано 29 января 2016 года.
- ↑ Granot et al. Mol Endocrinol. 2007 Sep;21(9):2164-77. Epub 2007 Jun 19. Дата обращения: 3 октября 2017. Архивировано 12 октября 2013 года.
- ↑ Fukuda et al. Cell. 2007 Apr 6;129(1):111-22. Дата обращения: 3 октября 2017. Архивировано 4 августа 2018 года.
- ↑ Bota and Davies. Nat Cell Biol. 2002 Sep;4(9):674-80. Дата обращения: 3 октября 2017. Архивировано 28 июля 2016 года.
- ↑ Gonzalez et al. Genes Dev. 1998 Dec 15;12(24):3889-99. Дата обращения: 3 октября 2017. Архивировано 12 октября 2013 года.
- ↑ Higashitani et al. Mol Gen Genet. 1997 Apr 28;254(4):351-7. Дата обращения: 3 октября 2017. Архивировано 12 октября 2013 года.
- ↑ Gur and Sauer Genes Dev. 2008 Aug 15;22(16):2267-77. doi: 10.1101/gad.1670908. Дата обращения: 3 октября 2017. Архивировано 7 апреля 2020 года.
- ↑ Gayda et al. J Bacteriol. 1985 Apr;162(1):271-5. Дата обращения: 3 октября 2017. Архивировано 10 апреля 2015 года.
- ↑ Hillard et al. J Biol Chem. 1998 Jan 2;273(1):518-23. Дата обращения: 3 октября 2017. Архивировано 12 октября 2013 года.
- ↑ saiSree et al. J Bacteriol. 2001 Dec;183(23):6943-6. Дата обращения: 3 октября 2017. Архивировано 12 октября 2013 года.
- ↑ E. coli genotypes, BL-21 (DE3). Дата обращения: 6 октября 2013. Архивировано 12 октября 2013 года.
- ↑ Ngo and Davies Ann N Y Acad Sci. 2007 Nov;1119:78-87. Дата обращения: 3 октября 2017. Архивировано 12 октября 2013 года.